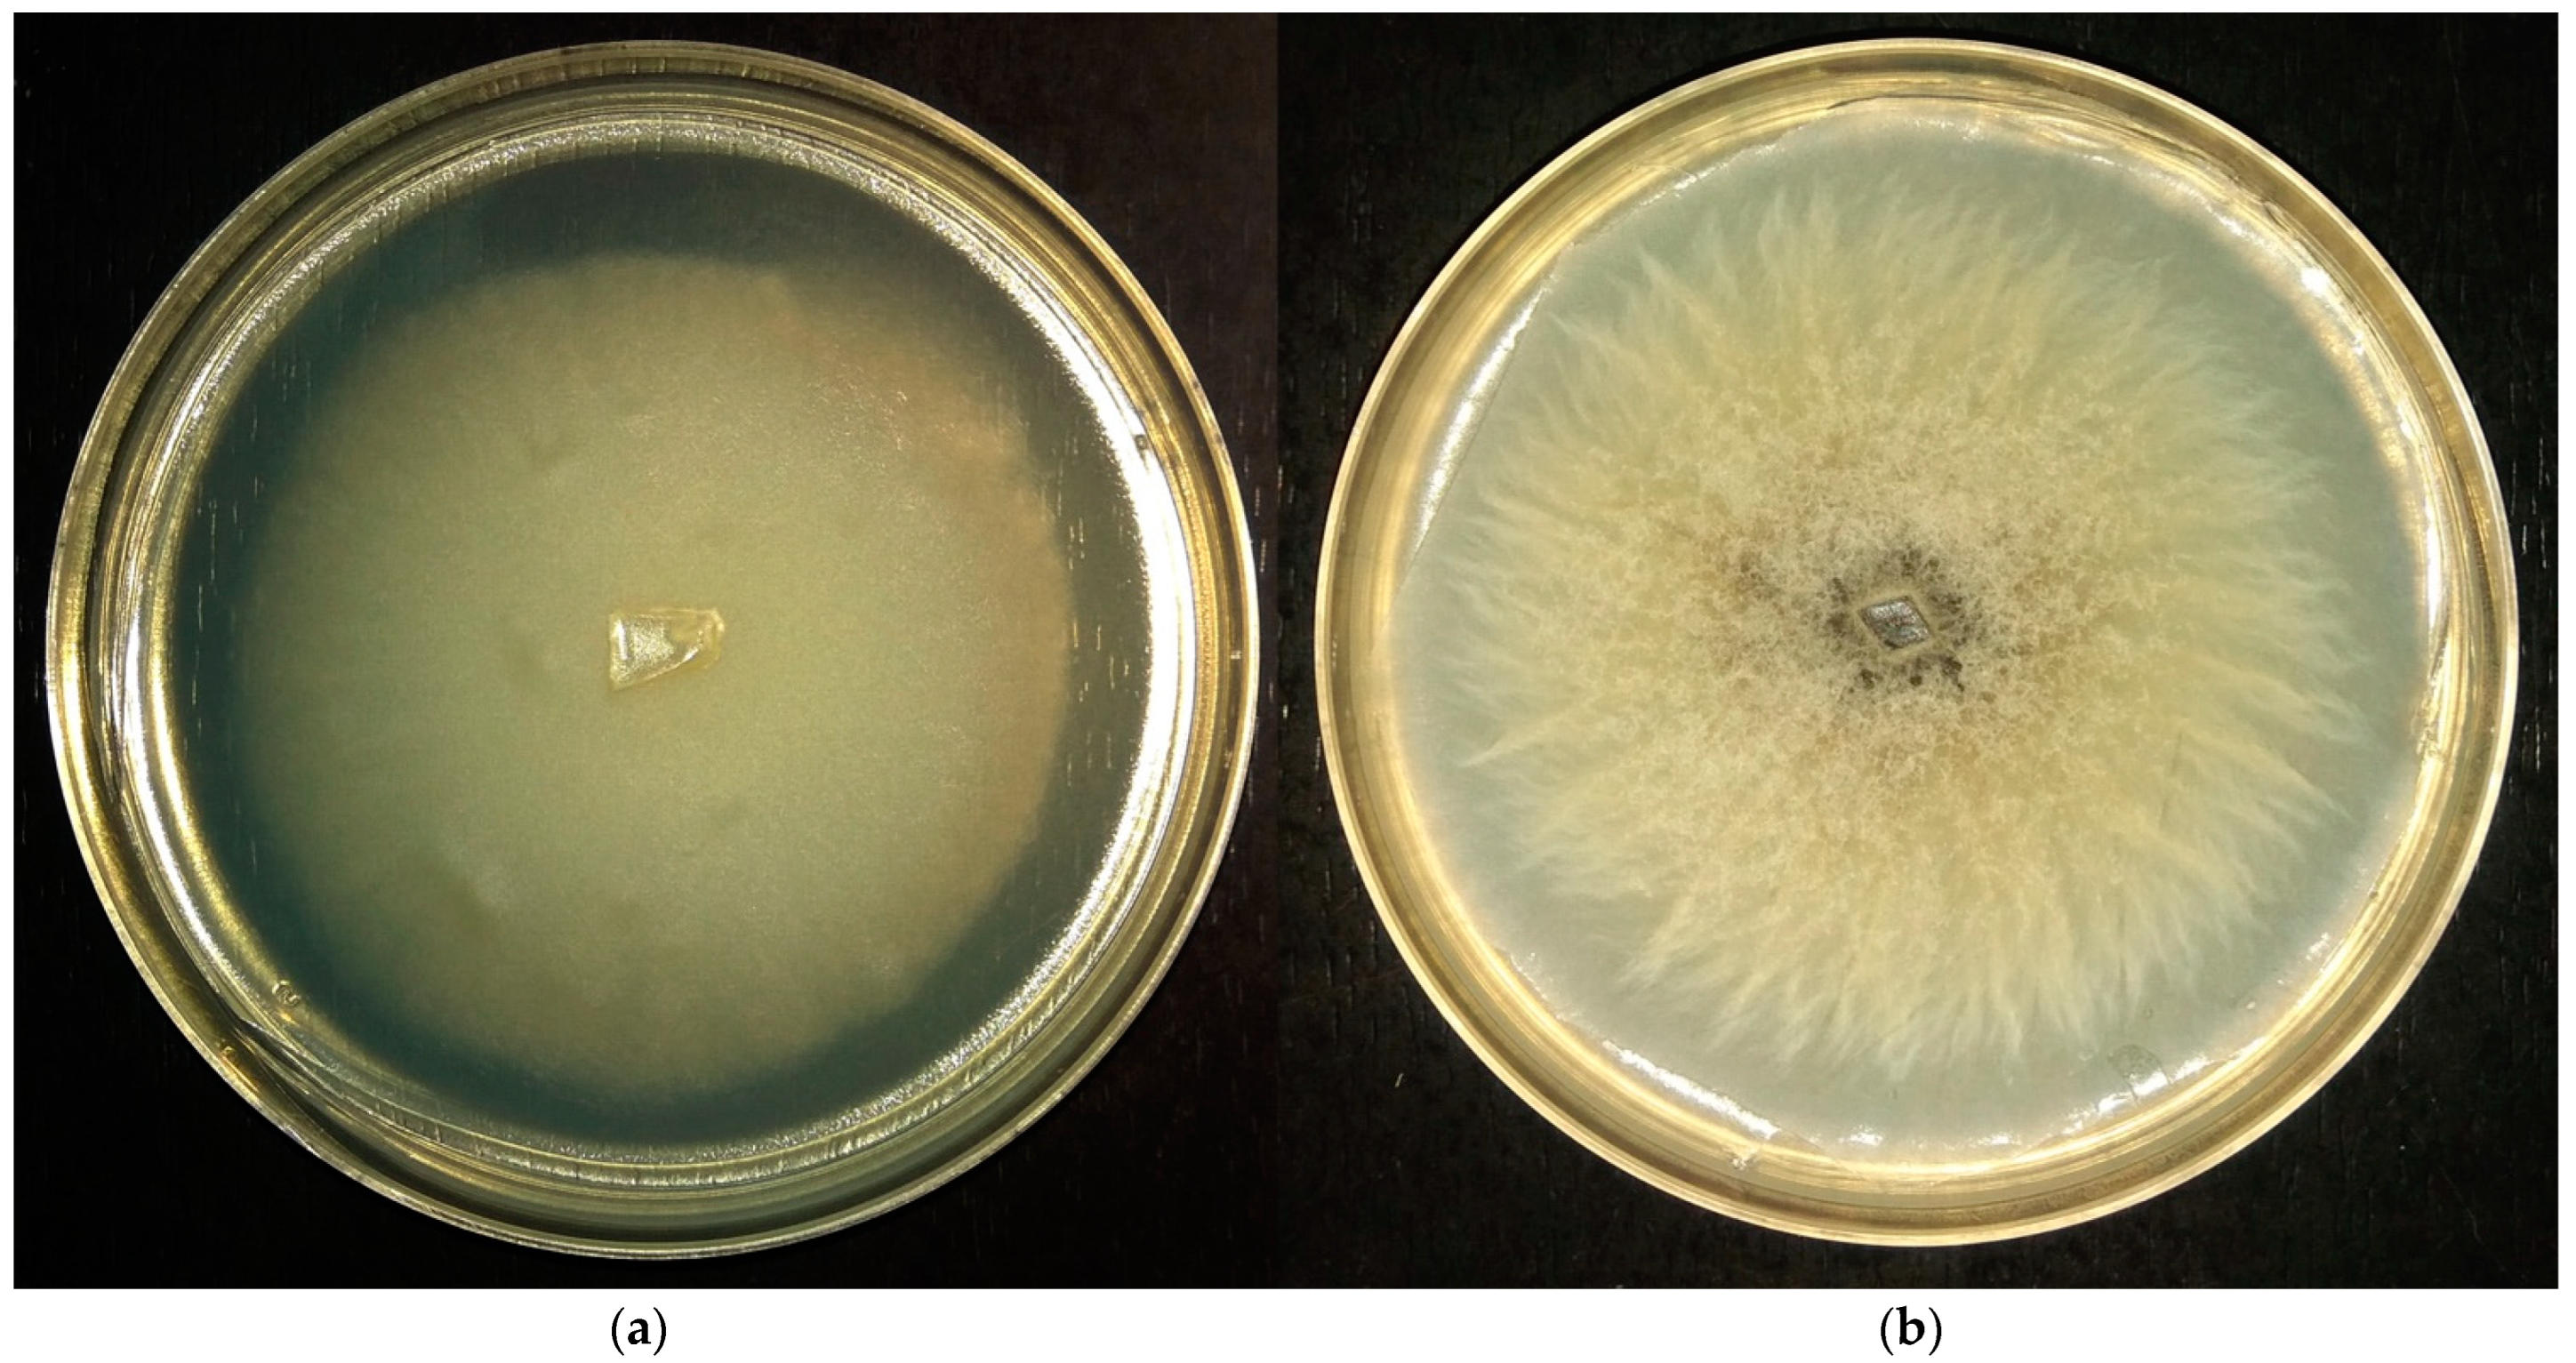
Microorganisms 11 01733 g001 Microorganisms 11 01733 g001

The Role of Osmolytes and Membrane Lipids in the Adaptation of Acidophilic Fungi
Abstract
1. Introduction
2. Materials and Methods
2.1. Objects of Study and Cultivation Protocol
2.2. Lipids, Carbohydrates and Polyols Analysis
2.3. Statistical Analysis
3. Results
3.1. Physiological Characteristics of Fungi
3.2. Composition of Carbohydrates and Polyols (CaP) of Cytosol in the Mycelium of Fungi under Optimal Conditions in Growth Dynamics and at Different pH
3.3. The Composition of Membrane Lipids under Optimal Conditions in the Growth Dynamics and at Different pH Values
3.4. The Composition of Storage Lipids under Optimal Conditions in the Growth Dynamics and at Different pH Values
3.5. The Fatty Acids Composition of Polar Lipids under Optimal Conditions in the Growth Dynamics and at Different pH Values
4. Discussion
5. Conclusions
Author Contributions
Funding
Institutional Review Board Statement
Data Availability Statement
Conflicts of Interest
References
- Coleine, C.; Stajich, J.E.; Selbmann, L. Fungi Are Key Players in Extreme Ecosystems. Trends Ecol. Evol. 2022, 37, 517–528. [Google Scholar] [CrossRef] [PubMed]
- Hallsworth, J.E.; Mancinelli, R.L.; Conley, C.A.; Dallas, T.D.; Rinaldi, T.; Davila, A.F.; Benison, K.C.; Rapoport, A.; Cavalazzi, B.; Selbmann, L.; et al. Astrobiology of Life on Earth. Environ. Microbiol. 2021, 23, 3335–3344. [Google Scholar] [CrossRef]
- Ibrar, M.; Ullah, M.W.; Manan, S.; Farooq, U.; Rafiq, M.; Hasan, F. Fungi from the Extremes of Life: An Untapped Treasure for Bioactive Compounds. Appl. Microbiol. Biotechnol. 2020, 104, 2777–2801. [Google Scholar] [CrossRef] [PubMed]
- Rothschild, L.J.; Mancinelli, R.L. Life in Extreme Environments. Nature 2001, 409, 1092–1101. [Google Scholar] [CrossRef] [PubMed]
- Gross, S.; Robbins, E.I. Acidophilic and Acid-Tolerant Fungi and Yeasts. Hydrobiologia 2000, 433, 91–109. [Google Scholar] [CrossRef]
- Segal-Kischinevzky, C.; Romero-Aguilar, L.; Alcaraz, L.D.; López-Ortiz, G.; Martínez-Castillo, B.; Torres-Ramírez, N.; Sandoval, G.; González, J. Yeasts Inhabiting Extreme Environments and Their Biotechnological Applications. Microorganisms 2022, 10, 794. [Google Scholar] [CrossRef] [PubMed]
- Amaral-Zettler, L.A. Eukaryotic Diversity at pH Extremes. Front. Microbiol. 2013, 3, 441. [Google Scholar] [CrossRef]
- Aguilera, A.; González-Toril, E. Eukaryotic Life in Extreme Environments: Acidophilic Fungi. In Fungi in Extreme Environments: Ecological Role and Biotechnological Significance; Springer International Publishing: Cham, Switzerland, 2019; pp. 21–38. [Google Scholar]
- Baker, B.J.; Tyson, G.W.; Goosherst, L.; Banfield, J.F. Insights into the Diversity of Eukaryotes in Acid Mine Drainage Biofilm Communities. Appl. Environ. Microbiol. 2009, 75, 2192–2199. [Google Scholar] [CrossRef]
- Rousk, J.; Brookes, P.C.; Bååth, E. Contrasting Soil PH Effects on Fungal and Bacterial Growth Suggest Functional Redundancy in Carbon Mineralization. Appl. Environ. Microbiol. 2009, 75, 1589–1596. [Google Scholar] [CrossRef]
- Coker, J.A. Recent Advances in Understanding Extremophiles. F1000Research 2019, 8, 1917. [Google Scholar] [CrossRef]
- Kane, P.M. Proton Transport and pH Control in Fungi. In Yeast Membrane Transport; Ramos, J., Sychrová, H., Kschischo, M., Eds.; Advances in Experimental Medicine and Biology; Springer: Cham, Switzerland, 2016; Volume 892, pp. 33–68. ISBN 978-3-319-25302-2. [Google Scholar]
- Ou, S.; Liang, J.-L.; Jiang, X.; Liao, B.; Jia, P.; Shu, W.; Li, J. Physiological, Genomic and Transcriptomic Analyses Reveal the Adaptation Mechanisms of Acidiella Bohemica to Extreme Acid Mine Drainage Environments. Front. Microbiol. 2021, 12, 705839. [Google Scholar] [CrossRef] [PubMed]
- Sánchez-Arreguin, J.A.; Ruiz-Herrera, J.; Mares-Rodriguez, F.d.J.; León-Ramírez, C.G.; Sánchez-Segura, L.; Zapata-Morín, P.A.; Coronado-Gallegos, J.; Aréchiga-Carvajal, E.T. Acid PH Strategy Adaptation through NRG1 in Ustilago Maydis. J. Fungi 2021, 7, 91. [Google Scholar] [CrossRef] [PubMed]
- Piper, P.W. The Heat Shock and Ethanol Stress Responses of Yeast Exhibit Extensive Similarity and Functional Overlap. FEMS Microbiol. Lett. 1995, 134, 121–127. [Google Scholar] [CrossRef]
- Fedoseeva, E.V.; Danilova, O.A.; Ianutsevich, E.A.; Terekhova, V.A.; Tereshina, V.M. Micromycete Lipids and Stress. Microbiology 2021, 90, 37–55. [Google Scholar] [CrossRef]
- Yancey, P.H. Organic Osmolytes as Compatible, Metabolic and Counteracting Cytoprotectants in High Osmolarity and Other Stresses. J. Exp. Biol. 2005, 208, 2819–2830. [Google Scholar] [CrossRef] [PubMed]
- Yancey, P.H.; Siebenaller, J.F. Co-Evolution of Proteins and Solutions: Protein Adaptation versus Cytoprotective Micromolecules and Their Roles in Marine Organisms. J. Exp. Biol. 2015, 218, 1880–1896. [Google Scholar] [CrossRef]
- Jennings, D.H. Polyol Metabolism in Fungi. In Advances in Microbial Physiology; Rose, A.H., Tempest, D.W., Eds.; Academic Press: London, UK, 1985; Volume 25, pp. 149–193. ISBN 0-12027725-4. [Google Scholar]
- Elbein, A.D.; Pan, Y.T.; Pastuszak, I.; Carroll, D. New Insights on Trehalose: A Multifunctional Molecule. Glycobiology 2003, 13, 17R–27R. [Google Scholar] [CrossRef]
- Iturriaga, G.; Suárez, R.; Nova-Franco, B. Trehalose Metabolism: From Osmoprotection to Signaling. Int. J. Mol. Sci. 2009, 10, 3793–3810. [Google Scholar] [CrossRef]
- Mattoon, E.R.; Casadevall, A.; Cordero, R.J. Beat the Heat: Correlates, Compounds, and Mechanisms Involved in Fungal Thermotolerance. Fungal Biol. Rev. 2021, 36, 60–75. [Google Scholar] [CrossRef]
- Tapia, H.; Koshland, D.E. Trehalose Is a Versatile and Long-Lived Chaperone for Desiccation Tolerance. Curr. Biol. 2014, 24, 2758–2766. [Google Scholar] [CrossRef]
- Costenoble, R.; Valadi, H.; Gustafsson, L.; Niklasson, C.; Johan Franzen, C. Microaerobic Glycerol Formation in Saccharomyces Cerevisiae. Yeast 2000, 16, 1483–1495. [Google Scholar] [CrossRef]
- Koide, R.T.; Shumway, D.L.; Stevens, C.M. Soluble Carbohydrates of Red Pine (Pinus Resinosa) Mycorrhizas and Mycorrhizal Fungi. Mycol. Res. 2000, 104, 834–840. [Google Scholar] [CrossRef]
- Gunde-Cimerman, N.; Plemenitaš, A.; Oren, A. Strategies of Adaptation of Microorganisms of the Three Domains of Life to High Salt Concentrations. FEMS Microbiol. Rev. 2018, 42, 353–375. [Google Scholar] [CrossRef]
- Inouye, M.; Phadtare, S. Cold-Shock Response and Adaptation to Near-Freezing Temperature in Cold-Adapted Yeasts. In Cold-Adapted Yeasts: Biodiversity, Adaptation Strategies and Biotechnological Significance; Buzzini, P., Margesin, R., Eds.; Springer Berlin Heidelberg: Berlin/Heidelberg, Germany, 2014; pp. 243–257. ISBN 978-3-642-39680-9. [Google Scholar]
- Nazareth, S.; Gonsalves, V. Aspergillus penicillioides—A True Halophile Existing in Hypersaline and Polyhaline Econiches. Ann. Microbiol. 2014, 64, 397–402. [Google Scholar] [CrossRef]
- Yanutsevich, E.A.; Memorskaya, A.S.; Groza, N.V.; Kochkina, G.A.; Tereshina, V.M. Heat Shock Response in the Thermophilic Fungus Rhizomucor miehei. Microbiology 2014, 83, 498–504. [Google Scholar] [CrossRef]
- Ianutsevich, E.A.; Danilova, O.A.; Groza, N.V.; Kotlova, E.R.; Tereshina, V.M. Heat Shock Response of Thermophilic Fungi: Membrane Lipids and Soluble Carbohydrates under Elevated Temperatures. Microbiology 2016, 162, 989–999. [Google Scholar] [CrossRef] [PubMed]
- Ianutsevich, E.A.; Danilova, O.A.; Kurilov, D.V.; Zavarzin, I.V.; Tereshina, V.M. Osmolytes and Membrane Lipids in Adaptive Response of Thermophilic Fungus Rhizomucor miehei to Cold, Osmotic and Oxidative Shocks. Extremophiles 2020, 24, 391–401. [Google Scholar] [CrossRef]
- Bondarenko, S.A.; Ianutsevich, E.A.; Danilova, O.A.; Grum-Grzhimaylo, A.A.; Kotlova, E.R.; Kamzolkina, O.V.; Bilanenko, E.N.; Tereshina, V.M. Membrane Lipids and Soluble Sugars Dynamics of the Alkaliphilic Fungus Sodiomyces Tronii in Response to Ambient PH. Extremophiles 2017, 21, 743–754. [Google Scholar] [CrossRef] [PubMed]
- Kozlova, M.V.; Ianutsevich, E.A.; Danilova, O.A.; Kamzolkina, O.V.; Tereshina, V.M. Lipids and Soluble Carbohydrates in the Mycelium and Ascomata of Alkaliphilic Fungus Sodiomyces alkalinus. Extremophiles 2019, 23, 487–494. [Google Scholar] [CrossRef]
- Ianutsevich, E.A.; Danilova, O.A.; Grum-Grzhimailo, O.A.; Groza, N.V.; Tereshina, V.M. Adaptation Of The Acidophilic Fungus Sistotrema brinkmannii to the pH Factor. Microbiology 2023, 92, 370–378. [Google Scholar] [CrossRef]
- Grum-Grzhimaylo, O.A.; Debets, A.J.M.; Bilanenko, E.N. The Diversity of Microfungi in Peatlands Originated from the White Sea. Mycologia 2016, 108, 233–254. [Google Scholar] [CrossRef] [PubMed]
- Nichols, B.W. Separation of the Lipids of Photosynthetic Tissues: Improvements in Analysis by Thin-Layer Chromatography. Biochim. Biophys. Acta—Spec. Sect. Lipids Relat. Subj. 1963, 70, 417–422. [Google Scholar] [CrossRef]
- Benning, C.; Huang, Z.H.; Gage, D.A. Accumulation of a Novel Glycolipid and a Betaine Lipid in Cells of Rhodobacter Sphaeroides Grown under Phosphate Limitation. Arch. Biochem. Biophys. 1995, 317, 103–111. [Google Scholar] [CrossRef]
- Kates, M. Techniques of Lipidology: Isolation, Analysis and Identification of Lipids. In Laboratory Techniques in Biochemistry and Molecular Biology; Work, T.S., Work, E., Eds.; North-Holland Publishing Company: Amsterdam, The Netherlands, 1972; Volume 3, pp. 267–610. ISBN 9780444533425. [Google Scholar]
- Agnew, M.P.; Craigie, C.R.; Weralupitiya, G.; Reis, M.M.; Johnson, P.L.; Reis, M.G. Comprehensive Evaluation of Parameters Affecting One-Step Method for Quantitative Analysis of Fatty Acids in Meat. Metabolites 2019, 9, 189. [Google Scholar] [CrossRef] [PubMed]
- Weete, J.D. Introduction to Fungal Lipids. In Fungal Lipid Biochemistry; Kritchevsky, D., Ed.; Springer US: Boston, MA, USA, 1974; Volume 1, pp. 3–36. ISBN 9781468428315. [Google Scholar]
- Somogyi, M. Determination Of Blood Sugar. J. Biol. Chem. 1945, 160, 69–73. [Google Scholar] [CrossRef]
- Brobst, K.M. Gas–Liquid Chromatography of Trimethylsilyl Derivatives: Analysis of Corn Syrup. In General Carbohydrate Method; Whistler, R.L., BeMiller, J.N., Eds.; Academic Press: New York, NY, USA; London, UK, 1972; pp. 3–8. ISBN 9780127462066. [Google Scholar]
- Magalhães, R.S.S.; Popova, B.; Braus, G.H.; Outeiro, T.F.; Eleutherio, E.C.A. The Trehalose Protective Mechanism during Thermal Stress in Saccharomyces Cerevisiae: The Roles of Ath1 and Agt1. FEMS Yeast Res. 2018, 18, foy066. [Google Scholar] [CrossRef]
- Baker-Austin, C.; Dopson, M. Life in Acid: pH Homeostasis in Acidophiles. Trends Microbiol. 2007, 15, 165–171. [Google Scholar] [CrossRef]
- Nguyen, V.A.T.; Senoo, K.; Mishima, T.; Hisamatsu, M. Multiple Tolerance of Rhodotorula glutinis R-1 to Acid, Aluminum Ion and Manganese Ion, and Its Unusual Ability of Neutralizing Acidic Medium. J. Biosci. Bioeng. 2001, 92, 366–371. [Google Scholar] [CrossRef]
- Tereshina, V.M.; Memorskaya, A.S.; Kotlova, E.R. The Effect of Different Heat Influences on Composition of Membrane Lipids and Cytosol Carbohydrates in Mycelial Fungi. Microbiology 2011, 80, 455–460. [Google Scholar] [CrossRef]
- Danilova, O.A.; Ianutsevich, E.A.; Bondarenko, S.A.; Antropova, A.B.; Tereshina, V.M. Membrane Lipids and Osmolytes Composition of Xerohalophilic Fungus Aspergillus penicillioides during Growth on High NaCl and Glycerol Media. Microbiology 2022, 91, 503–513. [Google Scholar] [CrossRef]
- Pokotylo, I.; Kravets, V.; Martinec, J.; Ruelland, E. The Phosphatidic Acid Paradox: Too Many Actions for One Molecule Class? Lessons from Plants. Prog. Lipid Res. 2018, 71, 43–53. [Google Scholar] [CrossRef] [PubMed]
- Carman, G.M.; Han, G.-S. Fat-Regulating Phosphatidic Acid Phosphatase: A Review of Its Roles and Regulation in Lipid Homeostasis. J. Lipid Res. 2019, 60, 2–6. [Google Scholar] [CrossRef] [PubMed]
- Liu, X.; Yin, Y.; Wu, J.; Liu, Z. Structure and Mechanism of an Intramembrane Liponucleotide Synthetase Central for Phospholipid Biosynthesis. Nat. Commun. 2014, 5, 4244. [Google Scholar] [CrossRef] [PubMed]
- Zhukovsky, M.A.; Filograna, A.; Luini, A.; Corda, D.; Valente, C. Phosphatidic Acid in Membrane Rearrangements. FEBS Lett. 2019, 593, 2428–2451. [Google Scholar] [CrossRef] [PubMed]
- McMahon, H.T.; Gallop, J.L. Membrane Curvature and Mechanisms of Dynamic Cell Membrane Remodelling. Nature 2005, 438, 590–596. [Google Scholar] [CrossRef] [PubMed]
- Kooijman, E.E.; Chupin, V.; de Kruijff, B.; Burger, K.N.J. Modulation of Membrane Curvature by Phosphatidic Acid and Lysophosphatidic Acid. Traffic 2003, 4, 162–174. [Google Scholar] [CrossRef]
- Zhou, H.; Huo, Y.; Yang, N.; Wei, T. Phosphatidic Acid: From Biophysical Properties to Diverse Functions. FEBS J. 2023, 1–16. [Google Scholar] [CrossRef]
- Danilova, O.A.; Ianutsevich, E.A.; Bondarenko, S.A.; Georgieva, M.L.; Vikchizhanina, D.A.; Groza, N.V.; Bilanenko, E.N.; Tereshina, V.M. Osmolytes and Membrane Lipids in the Adaptation of Micromycete Emericellopsis alkalina to Ambient PH and Sodium Chloride. Fungal Biol. 2020, 124, 884–891. [Google Scholar] [CrossRef]
- Péter, M.; Glatz, A.; Gudmann, P.; Gombos, I.; Török, Z.; Horváth, I.; Vígh, L.; Balogh, G. Metabolic Crosstalk between Membrane and Storage Lipids Facilitates Heat Stress Management in Schizosaccharomyces pombe. PLoS ONE 2017, 12, e0173739. [Google Scholar] [CrossRef]

| P. gigantea | Five Days, pH 4.0 | 10 Days, pH 4.0 | 14 Days, pH 4.0 | 14 Days, pH 2.6 | 14 Days, pH 5.0 |
|---|---|---|---|---|---|
| Membrane lipids | 7.1 ± 0.99 | 5.44 ± 0.2 | 4.39 ± 0.35 | 3.46 ± 0.35 | 5.24 ± 0.29 |
| Storage lipids | 6.7 ± 0.84 | 6.12 ± 1.18 | 5.53 ± 0.67 | 5.1 ± 0.28 | 5.02 ± 0.95 |
| Mollisia sp. | 12 days, pH 4.0 | 23 days, pH 4.0 | 35 days, pH 4.0 | 35 days, pH 2.6 | 35 days, pH 6.0 |
| Membrane lipids | 3.01 ± 0.18 | 2.44 ± 0.15 | 2.13 ± 0.25 | 2.5 ± 0.19 | 2.17 ± 0.26 |
| Storage lipids | 13.3 ± 1.34 | 16.61 ± 2.71 | 16.45 ± 3.64 | 16.4 ± 0.42 | 15.81 ± 0.85 |
| Fatty Acids | P. gigantea | Mollisia sp. | ||||||||
|---|---|---|---|---|---|---|---|---|---|---|
| 5 Days, pH4 | 10 Days, pH4 | 14 Days, pH4 | 14 Days, pH2.6 | 14 Days, pH5.0 | 12 Days, pH 4.0 | 23 Days, pH 4.0 | 35 Days, pH 4.0 | 35 Days, pH 2.6 | 35 Days, pH 6.0 | |
| C 14:0 (myristic) | 0.73 ± 0.05 | 0.63 ± 0.32 | 0.62 ± 0.31 | 0.84 ± 0.07 | 0.72 ± 0.05 | 0.24 ± 0.24 | 0.35 ± 0.35 | 0.31 ± 0.31 | 0 | 0 |
| C 14:1 (myristoleic) | 0.5 ± 0.27 | 0.33 ± 0.33 | 0.95 ± 0.49 | 1.09 ± 0.95 | 0.67 ± 0.55 | 1.22 ± 1.22 | 2.1 ± 2.1 | 1.02 ± 1.02 | 13.1 ± 4.08 (*) | 10.69 ± 5.35 (*) |
| C 15:0 (pentadecylic) | 1.16 ± 0.18 | 2.37 ± 0.52 | 2.27 ± 0.44 | 0.5 ± 0.39 | 1.14 ± 0.51 | 0.1 ± 0.1 | 0.13 ± 0.13 | 0 | 0.34 ± 0.17 | 0 |
| C 16:0 (palmitic) | 19.47 ± 1.12 | 19.04 ± 1.48 | 19.37 ± 0.51 | 18.42 ± 0.85 | 18.87 ± 0.32 | 19.84 ± 1.86 | 21.68 ± 1.25 | 20.64 ± 1.23 | 20.18 ± 2.19 | 14.98 ± 0.53 (*) |
| C 16:1 (palmitoleic) | 0.97 ± 0.16 | 0.53 ± 0.28 | 0.84 ± 0.28 | 1.01 ± 0.16 | 1 ± 0.15 | 0.14 ± 0.14 | 0.17 ± 0.17 | 0.09 ± 0.09 | 0 | 0 |
| C 17:0 (margaric) | 0.72 ± 0.19 | 0.65 ± 0.34 | 0.92 ± 0.13 | 0.49 ± 0.1 | 0.5 ± 0.19 | 1.65 ± 0.86 | 2.25 ± 1.14 | 2.17 ± 1.23 | 1.23 ± 0.62 | 1.34 ± 0.67 |
| C 17:1 (heptadecenoic) | 0.4 ± 0.03 | 0.3 ± 0.15 | 0.25 ± 0.12 | 0.32 ± 0.02 | 0.33 ± 0 | 0.23 ± 0.23 | 1.27 ± 0.87 | 1.31 ± 1.03 | 0 | 0 |
| C 18:0 (stearic) | 1.18 ± 0.02 | 1.2 ± 0.4 | 1.18 ± 0.41 | 0.94 ± 0.06 | 1.14 ± 0.1 | 1.65 ± 0.21 | 1.14 ± 0.12 | 1.3 ± 0.28 | 1.48 ± 0.3 | 1.38 ± 0.13 |
| C 18:1n9c (oleic) | 3.75 ± 0.26 | 3.12 ± 0.1 | 4.08 ± 1.57 | 4.54 ± 0.41 | 5 ± 0.37 | 19.88 ± 2.75 | 26.1 ± 1.45 | 32.22 ± 2.55 | 32.83 ± 2.64 | 28.09 ± 1.42 |
| C 18:2n6c (linoleic) | 71.05 ± 1.58 | 71.84 ± 2.6 | 69.46 ± 1.19 | 71.81 ± 2.03 | 70.58 ± 0.81 | 54.4 ± 3.94 | 44.7 ± 0.98 | 40.94 ± 2.18 | 30.85 ± 0.33 (*) | 43.51 ± 3.94 |
| C 18:3n3 (linolenic) | 0.06 ± 0.06 | 0 | 0.07 ± 0.07 | 0.05 ± 0.05 | 0.06 ± 0.06 | 0.65 ± 0.05 | 0.12 ± 0.12 | 0 | 0 | 0 |
| Degree of unsaturation | 1.48 ± 0.03 | 1.48 ± 0.05 | 1.45 ± 0.01 | 1.51 ± 0.03 | 1.48 ± 0.01 | 1.32 ± 0.05 | 1.19 ± 0.04 | 1.17 ± 0.05 | 1.08 ± 0.01 | 1.26 ± 0.04 |
Disclaimer/Publisher’s Note: The statements, opinions and data contained in all publications are solely those of the individual author(s) and contributor(s) and not of MDPI and/or the editor(s). MDPI and/or the editor(s) disclaim responsibility for any injury to people or property resulting from any ideas, methods, instructions or products referred to in the content. |
© 2023 by the authors. Licensee MDPI, Basel, Switzerland. This article is an open access article distributed under the terms and conditions of the Creative Commons Attribution (CC BY) license (https://creativecommons.org/licenses/by/4.0/).
Share and Cite
Ianutsevich, E.A.; Danilova, O.A.; Grum-Grzhimaylo, O.A.; Tereshina, V.M. The Role of Osmolytes and Membrane Lipids in the Adaptation of Acidophilic Fungi. Microorganisms 2023, 11, 1733. https://doi.org/10.3390/microorganisms11071733
Ianutsevich EA, Danilova OA, Grum-Grzhimaylo OA, Tereshina VM. The Role of Osmolytes and Membrane Lipids in the Adaptation of Acidophilic Fungi. Microorganisms. 2023; 11(7):1733. https://doi.org/10.3390/microorganisms11071733
Chicago/Turabian StyleIanutsevich, Elena A., Olga A. Danilova, Olga A. Grum-Grzhimaylo, and Vera M. Tereshina. 2023. "The Role of Osmolytes and Membrane Lipids in the Adaptation of Acidophilic Fungi" Microorganisms 11, no. 7: 1733. https://doi.org/10.3390/microorganisms11071733
APA StyleIanutsevich, E. A., Danilova, O. A., Grum-Grzhimaylo, O. A., & Tereshina, V. M. (2023). The Role of Osmolytes and Membrane Lipids in the Adaptation of Acidophilic Fungi. Microorganisms, 11(7), 1733. https://doi.org/10.3390/microorganisms11071733

